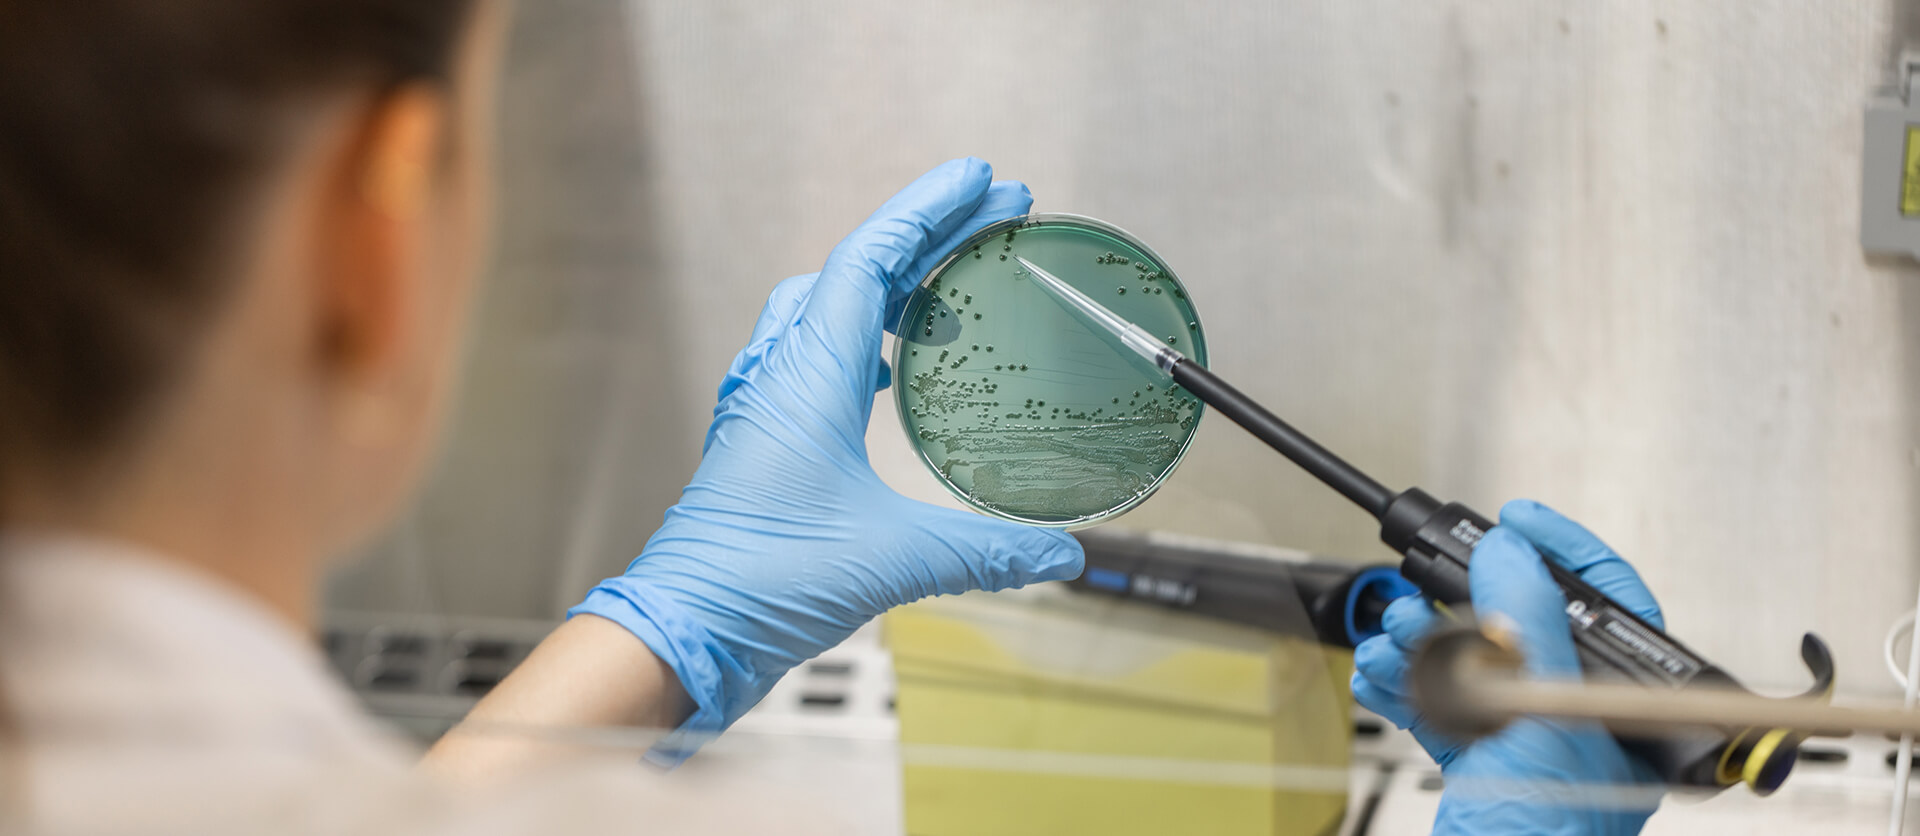

News connecting research and society
Latest news
Agrotecnio's news coverage highlights the centre's main advances and milestones. It raises the profile of research activity, participation in projects and awards won by research groups, both nationally and internationally.
With a perspective committed to society and the region, our news also highlights the specific impacts generated by the centre's research, from knowledge transfer to responding to global challenges in the food system.

04/06/2026
A Catalan project investigates how to harness bovine transition milk for human and animal nutrition
Read news

02/06/2026
Two studies by Agrotecnio and the University of Lleida win awards at the International Congress on Bovine Medicine
Read news

27/05/2026
CSIC ranks 9 Agrotecnio researchers among the most influential in Spain
Read news

26/05/2026
Agrotecnio and IRBLleida launch the third Agrohealth call for proposals
Read news

21/05/2026
Drones, an ideal tool for phytosanitary treatments in vineyards
Read news

15/05/2026
Gabriel de la Fuente, Agrotecnio researcher, will open Pint of Science Lleida on 18 May
Read news

14/05/2026
Drones and mites to control corn red spider mites
Read news

08/05/2026
Almond, walnut and grape residues, an alternative for weed control in vineyards
Read news

04/05/2026
Extreme heat threatens malting barley: ResOrMa identifies key factors for making it more resilient
Read news

21/04/2026
Agrotecnio drives multidisciplinary projects to accelerate agri-food innovation
Read news

13/04/2026
Barley, stronger in the face of climate change: results workshop of the ResOrMa project
Read news

10/04/2026
Artificial intelligence and drones to select the most resilient wheat
Read news